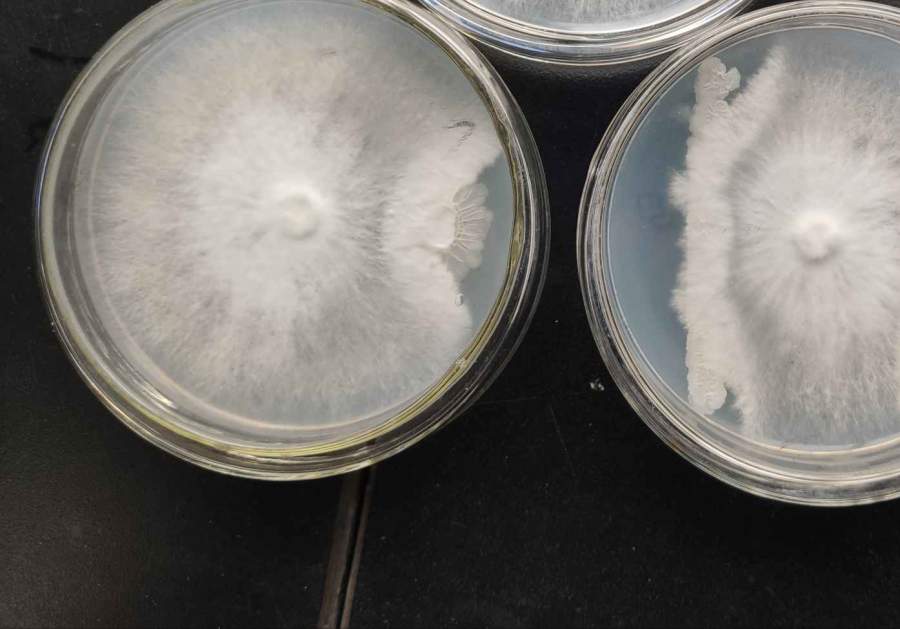
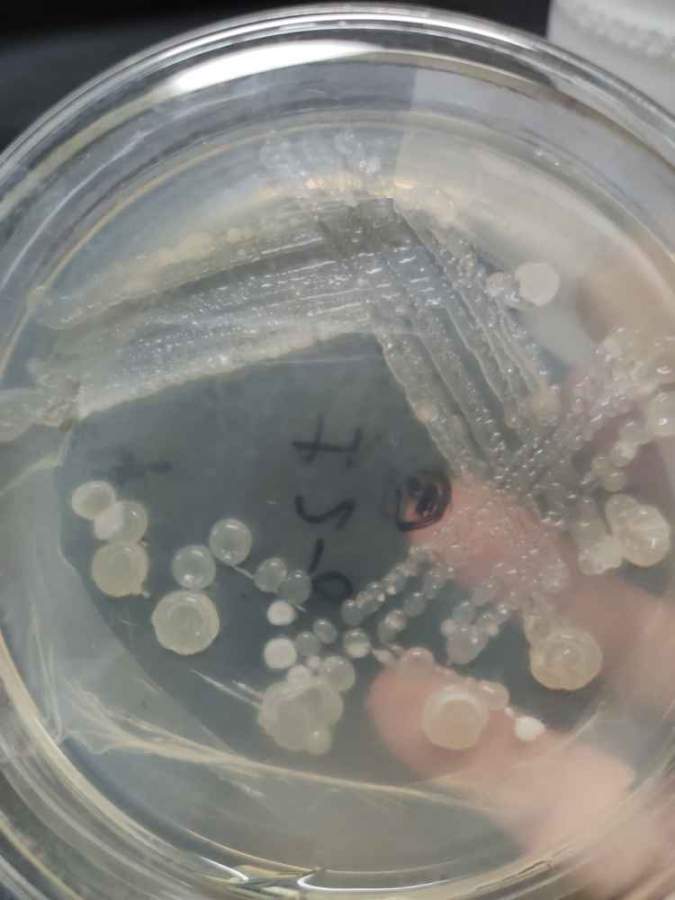

用解淀粉芽孢杆菌做生防方面的课题
TT09641466
目前解淀粉芽孢杆菌做的已经很多了,但是现在实验室可供我使用做毕业论文的只有这一株菌,目前的思路是:发酵——提取抗菌物质——盆栽,但是这个思路没有什么新意且基本都是这个思路,想请问还有没有别的思路可做?希望各位赐教一二,谢谢!
微生物
- 300
- 6
光合细菌纯化液体培养难以变红
wsliuleilei
我前段时间把里面光合菌种纯化出来了,因为买的里面有杂菌嘛。结果发现纯化出来的没有杂菌的菌液反而长不红,有杂菌的怎么培养都很红,这个你们那有遇到过呢?怎么解释这种现象啊?之前总以为纯化出来万事大吉,现在发现不纯时划线光合细菌和杂菌长在一起还很和谐,纯种单独划线还...
微生物
- 450
- 9
请问如何测定细菌细胞膜中环丙烷脂肪酸?
wangshumin55
在文献中看到很多文献报道,细菌细胞膜中含有环丙烷脂肪酸,报道最多的是C19cyc,有些文献中指出采用外标法,但是我咨询了一些检测公司以及供货商,答复都是没有环丙烷脂肪酸的标准品,此外检测公司采用外标法也只能检测除环丙烷脂肪酸外的其他饱和和不饱和脂肪酸。求助各位...
微生物
- 250
- 5

京公网安备 11010802022153号
京公网安备 11010802022153号